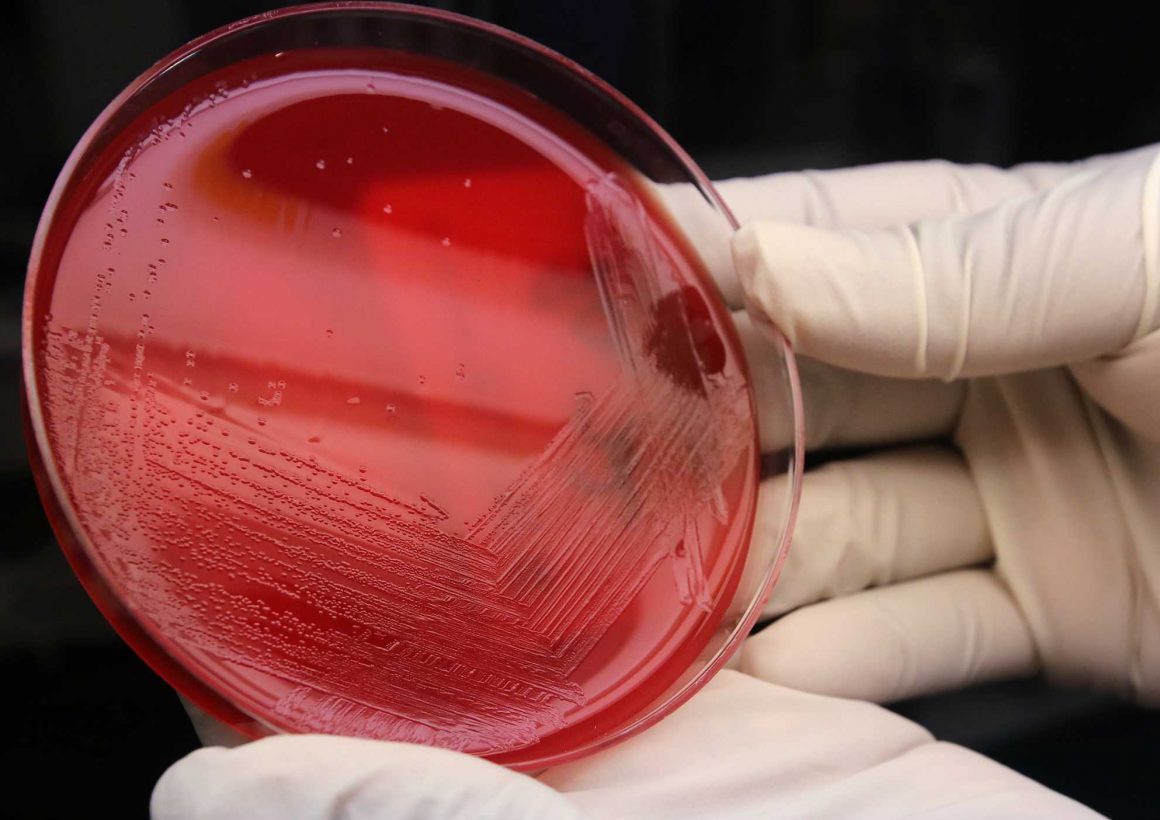
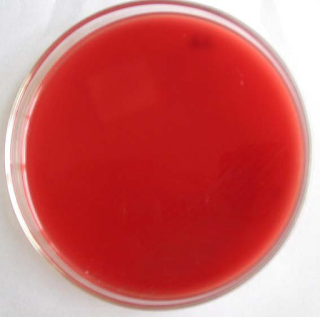

Agar darah merupakan media diferensial,bukan media selektif. Darah agar memungkinkan membedakan bakteri berdasarkan kemampuan mereka untuk melisiskan sel-sel darah merah....
Jual Darah Domba / Blood Agar Base Kualitas Terbaik
Darah Domba adalah bahan yang sangat diperlukan dalam pembuatan
berbagaimedia hidup di Laboratorium Mikrobiologi, diantaranya :
Agar Darah, Blood Agar Base, Agar Coklat, Agar Mac Conkey, Agar Darah Telurit,
Sabouraud Maltose/Dextrose Agar, Agar Brucella, Endo Agar, dll
Darah Domba dengan kualitas terjaga!
Produk Darah Domba dihasilkan dari domba yang sehat serta diperlakukan dengan baik, dan darah domba hasil transfusi dijaga kualitasnya dengan peralatan standar medis.
Penyimpanan dan Kelola Darah Domba yang Profesional
Mengelola penyimpanan darah domba hasil transfusi dengan profesional untuk menjaga kualitas dari produk darah domba tersebut.


Packing dan Pengiriman Darah Domba Profesional
Packing dan pengiriman darah domba kepada konsumen dilakukan dengan standar pengirimn yang baik dan memenuhi unsur keselamatan dan keamanan.
PT GM Indotama
Kami adalah suplier dan penyedia darah domba untuk bahan dasar Media Agar sebagai media hidup untuk mikro organisme bagi keperluan penelitian Rumah Sakit, Perusahaan Farmasi, Laboratorium Mikrobiologi, dan bagi kepentingan penelitian lainnya.
Produk darah domba kami dihasilkan dari sumber yang terjamin kesehatannya, kebersihannya, dan prosedur pengambilan darah dilakukan dengan cara dan peralatan standar medis. Penyimpanan darah domba hasil transfusi juga dilakukan dengan standar dan petunjuk medis dalam penanganan darah, serta pengiriman kepada klien juga dilakukan secara profesional dan standar pengiriman bahan-bahan medis.
Artikel
MEDIA BLOOD AGAR PLATE
Media Blood Agar merupakan media pertumbuhan bakteri yang dapat membedakan bakteri pathogen berdasarkan efek exotoksin hemolitik bakteri pada sel darah...